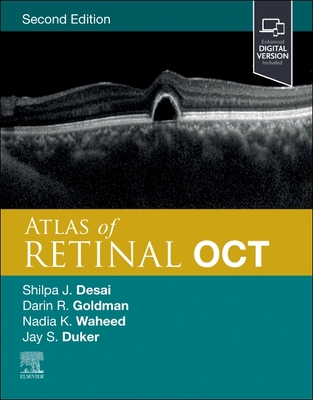
Image for Atlas of Retinal OCT: Optical Coherence Tomography Atlas of Retinal OCT: Optical Coherence Tomography

Comas-diaz, Lillian,Abdulrehman, Rehman,Wedding, Danny





Stranieri, Andrew

Katz-Buonincontro PhD, Jen

Visvader, Jane E.,Rosen, Jeffrey M.,Aparicio, Samuel

Parthasarathy, Krupakar




Ocklenburg, Sebastian,Gntrkn, Onur




Default Sort attempts to select a random list for the listing of items.